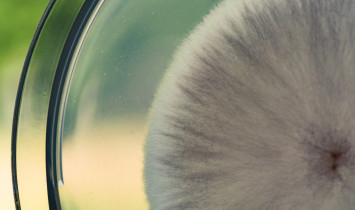
schimmel

Garbeva Group
Garbeva Group
Microbial EcologyGroup members
Senior Research Group:
Garbeva Group
The focus of Garbeva research group is to understand the fundamental mechanisms of microbe-microbe and plant-microbe communication and interactions with particular attention to the role of microbial volatiles. Microbial volatiles are chemically very diverse and play important roles in long-distance interactions and communication. Volatiles can diffuse fast in both gas- and water phase and hence, mediate swift chemical interactions. Next to the constitutively emitted volatiles, microbes can emit induced volatiles that are triggered by microbial interspecific interactions. In terms of biological functions, microbial volatiles are able to affect many different types of target organisms, such as bacteria, fungi, protists, plants, or animals.